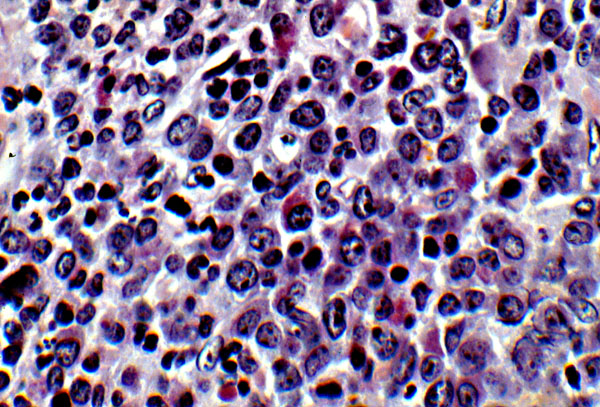

Granulocytic sarcoma, histology
Click picture to enlarge. Close window to return
Granulocytic sarcoma is an extramedullary proliferation of neoplastic hematopoietic cells. It can show various stages of maturation. In this slide, there is a mononuclear cell infiltrate composed of fairly undifferentiated cells. Admixed eosinophilic myelocytes are present, which are often a histologic clue to the diagnosis of granulocytic sarcoma.